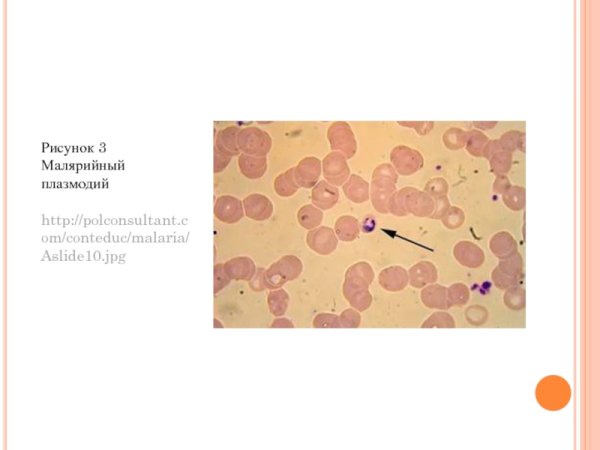
Pathogen for malaria

Малярийный плазмодий - это простейший микроорганизм, вызывающий заболевание малярия у человека. Он представляет собой паразитический организм, который передается через укусы комаров. Рисунок малярийного плазмодия может быть полезным для визуализации его внешнего вида и структуры, что поможет лучше понять этот патоген и способы борьбы с ним. Такой рисунок может использоваться в образовательных материалах, научных исследованиях и медицинских презентациях, чтобы донести информацию о малярийном плазмодии широкой аудитории.
Малярийный плазмодий строение
Плазмодий паразит
Малярийный плазмодий стро
Малярийный плазмодий структура клетки
Одноклеточный малярийный плазмодий
Малярийный плазмодий циста
Споровики малярийный плазмодий
Малярийный плазмодий строение
Малярийный плазмодий строение
Малярийный плазмодий строение
Апикомплексы Споровики
Малярийный плазмодий и токсоплазма
Споровики малярийный плазмодий
Малярийный плазмодий стро
Plasmodium malariae строение
Малярийные плазмодии Plasmodium
Строение малярного плазмодия
Малярийный плазмодий шизонт рисунок
Малярийный плазмодий строение
Строение малярного плазмодия
Малярийный плазмодий
Малярийный плазмодий строение рисунок
Жизненный цикл малярийного плазмодия
Окончательный хозяин малярийного плазмодия
Стадии развития малярийного комара
Малярийный плазмодий
Малярийный плазмодий Тип класс
Plasmodium malariae строение
Pathogen for malaria
Малярийный плазмодий строение 5 класс
Малярийный плазмодий строение
Малярийный плазмодий жизненный цикл промежуточный хозяин
Малярийный плазмодий и токсоплазма
Малярийный плазмодий
Малярийный плазмодий строение
Споровики строение клетки
Малярийный плазмодий строение
Plasmodium malariae строение
Стадии развития плазмодия в эритроците
Plasmodium falciparum шизонт
Plasmodium falciparum на стадии кольца
Малярийный плазмодий в организме человека паразитирует в:
Схема заражения малярийного плазмодия
Цикл размножения малярийного плазмодия
Споровики малярийный плазмодий
Малярийный плазмодий жизненный цикл промежуточный хозяин

Grizly.club
Grizly.club